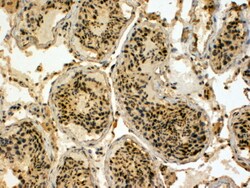

Promotional price valid on web orders only. Your contract pricing may differ. Interested in signing up for a dedicated account number?
Learn More
Learn More
Invitrogen™ HYD Polyclonal Antibody


Goat Polyclonal Antibody
Supplier: Invitrogen™ PA5142051
This item is not returnable.
View return policy
Description
This antibody is tested in Peptide ELISA: antibody detection limit dilution 1:4,000.
EDD (for E3 identified by Differential Display) is a progestin-regulated gene that was isolated from T-47D human breast cancer cells. Based on sequence homology, EDD appears to be a human homolog of the Drosophila hyperplastic discs (hyd) gene, a tumor suppressor gene that is required for control of imaginal disc growth. EDD contains a HECT domain in the carboxy terminus. HECT domain-containing proteins function as ubiquitin-protein ligases, or E3 enzymes. EDD has been shown to bind to ubiquitin, and like other HECT family proteins, may function as an E3 ubiquitin-protein ligase.
Specifications
| HYD | |
| Polyclonal | |
| Unconjugated | |
| UBR5 | |
| CH D1S3362; DD5; E3 identified by differential display; E3 ubiquitin-protein ligase UBR5; E3 ubiquitin-protein ligase, HECT domain-containing 1; ECGF1; Edd; Edd1; EDG1; EDG-1; extraembryonic development; HECT-type E3 ubiquitin transferase UBR5; hHYD; HYD; Hyperplastic discs protein homolog; KIAA0896; Progestin-induced protein; Rat100; S1P receptor 1; S1P receptor Edg-1; S1P1; S1PR1; ubiquitin protein ligase E3 component n-recognin 5; Ubr5 | |
| Goat | |
| Ammonium sulfate precipitation | |
| RUO | |
| 51366 | |
| -20°C, Avoid Freeze/Thaw Cycles | |
| Liquid |
| Immunohistochemistry (Paraffin) | |
| 0.5 mg/mL | |
| TBS with 0.5% BSA and 0.02% sodium azide; pH 7.3 | |
| O95071 | |
| UBR5 | |
| Peptide with sequence C-LAIKTKNFGFV. | |
| 100 μg | |
| Primary | |
| Human | |
| Antibody | |
| IgG |
Product Content Correction
Your input is important to us. Please complete this form to provide feedback related to the content on this product.
Product Title
Spot an opportunity for improvement?Share a Content Correction